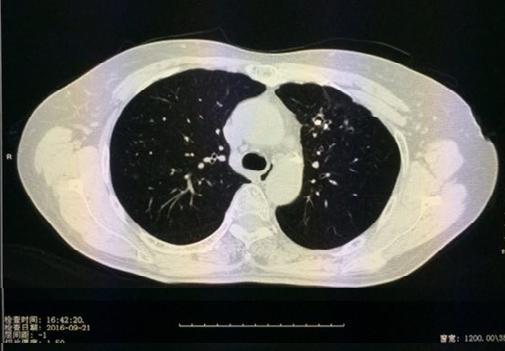

随着生活水平的不断提高,人们对健康的重视程度越来越高,为实现对呼吸系统疑难病、危重症及慢性病的精准诊治及全程化管理,以提高疗效和改善患者生活质量,西安市胸科医院呼吸与危重症医学科开设了呼吸专病门诊。
呼吸专病门诊介绍

01
肺结节一站式综合门诊
肺部结节是指≤3cm的肺部圆形病变,无卫星灶、无淋巴结及远处播散。肺部小结节是指≤1cm的结节,又称亚厘米结节。还有一个经常在肺部CT检查影像报告上看到的术语GGO,它是指肺部磨玻璃结节,是一种特殊类型的肺部结节,表现为密度轻度增高的云露状淡薄影/圆形结节,样子像磨砂玻璃一样,所以叫磨玻璃影。研究表明,18%-63%的毛玻璃样小结节是早期肺癌;肺部结节可以是弥漫性散生长,也可以仅聚集在局部。一般而言,弥漫性生长的结节良性病变的可能性大,局灶性生长的容易是肺部肿瘤。
西安交通大学附属胸科医院(西安市胸科医院)呼吸与危重症医学科设立 “肺结节一站式“综合门诊,构建并优化了肺结节/肺癌精准诊治体系,为就诊患者提供“一站式”服务:网上预约挂号-影像学检查-三维重建数字肺分析-必要时气管镜/内科胸腔镜检查-制定治疗建议-随访;同时,对于疑难肺结节患者,将由呼吸与危重症医学科、胸外科、肿瘤科等多学科专家共同商讨和制定个性化治疗方案,提高肺结节诊断的准确率,真正实现“病人不乱跑、医生围着病人转”的一站式服务。
西安的赵师傅就是该院“一站式”服务的受益者。前不久他体检时被查出肺部有个“结节”,对此他非常恐慌,立即前往多家三甲医院挂号,在多个科室反复奔波、但看了半天,却难于确诊。后听人介绍说西安市胸科医院新近来了一批业务水平很高的呼吸与危重症医学科、肿瘤科、胸外科专家,便来该院肺结节/肺癌一站式综合门诊,结果仅一天时间,他便被确诊患了良性结节,定期随访,令他久悬着的心放了下来。“总算能睡个好觉了!”赵师傅说,之前跑了多家医院,没想到在胸科医院挂一个号就很快得出结论,真太方便了。
病例1: 巩先生,体检发现左肺毛玻璃小结节,用EBUS-GS超声支气管镜进行检查,病理结果:隐球菌感染。


病例2 李某 因面部浮肿,胸部CT显示纵隔淋巴结多处肿大,经过EBUS-TBNA(经支气管粘膜超声纵隔淋巴结穿刺术),取出标本,病理证实为”纵隔淋巴结肉芽肿”,符合结核,抗结核治疗1月后明显好转。


02
慢阻肺门诊
慢阻肺,老百姓俗称“肺气肿”,是慢性阻塞性肺疾病的简称,是一种以持续气流受限为特征的全身性疾病,在秋冬季容易出现病情急性加重。而吸烟会导致慢阻肺,包括肺气肿和慢性支气管炎;研究表明,女性吸烟者更易患慢阻肺,吸烟者死于慢阻肺的可能性是不吸烟者的12-13倍;因此,尽早戒烟十分必要。慢阻肺、哮喘是我国呼吸系统最常见的慢性病,这是一种需要像高血压,糖尿病一样终生管理的可防可控的疾病。慢阻肺的主要症状有慢性咳嗽、咳痰、气短或呼吸困难等,部分患者特别是重度患者或急性加重时出现喘息和胸闷。对慢阻肺患者来说,早诊重要,治疗更要及时。
西安交通大学附属胸科医院(西安市胸科医院)呼吸与危重症科目前已形成了慢阻肺全程一体化管理体系,免费进行慢病诊前评估,目的是慢阻肺患者从早期疑诊、筛查到规范诊治和终末期管理都能够有专人负责,最大程度地改善慢阻肺患者生活质量,减轻患者疾病痛苦,延长患者生命。
03
咳嗽门诊
咳嗽是导致内科门诊患者就诊的最常见症状之一,根据持续时间不同,将咳嗽分为急性咳嗽(<3周)、亚急性咳嗽(3-8周)和慢性咳嗽(>8周)三种类型,急性咳嗽若迁延不愈则可转变为亚急性或慢性咳嗽;急性咳嗽常见于感冒、急性支气管炎等等;亚急性咳嗽常见于感染后咳嗽;大部分慢咳患者X线和CT是正常的,仅仅以咳嗽为主要或唯一症状者,其原因有很多,最常见的是:咳嗽变异性哮喘、上气道咳嗽综合征、嗜酸粒细胞性支气管炎、胃食管反流病等等,咳嗽变异性哮喘是哮喘的一种特殊类型,咳嗽是其唯一或主要临床表现,无明显喘息、气促等症状或体征,但存在气道高反应性这个哮喘的特殊病理生理学现象,如果不及时治疗,部分病人会发展成为典型的哮喘,大约三分之一的慢性咳嗽是这个疾病造成的,常规肺功能的支气管激发试验或支气管舒张试验能够很好的诊断。频繁剧烈的咳嗽也会对患者的工作、生活和社会活动造成严重影响。咳嗽不是一个小毛病,不是自己随便买些止咳糖浆就能解决问题的。咳嗽的病因不同,治疗方法也不同。所以,一旦出现咳嗽,一定要看医生,明确诊断以后才能服药。
西安交通大学附属胸科医院(西安市胸科医院)呼吸与危重症医学科配备了包括一氧化氮检测、肺功能检测、诱导痰检查、支气管镜检查等在内的多种相关技术,具有规范化诊治咳嗽的完善体系。
病例1:马大姐,咳嗽近1年,外院抗结核治疗半年无效,来我院就诊,经支气管镜检查后确诊为”支气管结石”,经过治疗后咳嗽消失。

04
哮喘门诊
哮喘是一种气道慢性炎症性疾病,具有反复发作的喘息、气促、胸闷和(或)咳嗽等症状。发作性伴有哮鸣音的呼气性呼吸困难或发作性咳嗽、胸闷。严重者被迫采取坐位或呈端坐呼吸,甚至出现发绀等。哮喘症状可在数分钟内发作,经数小时至数天,用支气管舒张剂或自行缓解;某些患者在缓解数小时后可再次发作。
西安交通大学附属胸科医院(西安市胸科医院)呼吸与危重症医学科一直致力于慢性气道疾病(哮喘、慢阻肺)的基础和临床研究,对支气管哮喘的治疗和管理有着丰富的经验。
病例2王某,难治性哮喘3年,支气管镜下见散在粘膜小结节,经过检查确诊为”嗜酸性肉芽肿性血管炎”,经治疗后康复,复查支气管镜粘膜恢复正常。


05
呼吸道感染门诊
呼吸道感染是指致病微生物侵入呼吸道并进行繁殖导致的疾病。根据其部位分为上呼吸道感染和下呼吸道感染。前者包括鼻炎、咽炎和喉炎;后者包括气管炎、支气管炎和肺炎。而复杂肺部感染是引起呼吸衰竭的重要原因,严重可导致败血症、休克、多脏器功能衰竭,甚至危及生命,致病病原体的鉴定是治疗与用药的关键。
西安交通大学附属胸科医院(西安市胸科医院)呼吸与危重症医学科依托精准实验室,以呼吸介入技术为手段,着力打造复杂肺部感染精准诊治体系,包括样本采集、实验室检测方法、病原学检测方法等流程优化,实现复杂感染的高效、快速、精准诊治,显著提高不明原因发热、慢性肺部感染、重症肺炎、脓毒症诊治水平。
06
良/恶性气道狭窄门诊
气道狭窄由指气管、主支气管和右中间段支气管病变引起的狭窄。病因多有结核、肿瘤、结节病、软骨炎等,中央型气道狭窄病人临床表现主要为进行性喘息症状加重,常引起呼吸衰竭或窒息而导致患者死亡。诊断常需影像学及气管镜检查可确诊。良性气道狭窄患者及家属的期望值较高,常常希望获得长期症状的缓解。手术是传统的治疗方法,但手术本身有许多风险,且许多病人由于本身病变特点或心肺功能不全等原因不适宜或不能耐受手术。随着气管镜介入治疗的不断发展,许多以往需要手术或无法手术治疗的一些气道狭窄病变都可以借助支气管镜介入治疗获得满意疗效。西安市胸科医院呼吸与危重症医学科开展支气管镜下冷冻、氩气、激光、光动力、球囊扩张、支架置入等多种高端技术,为患者改善呼吸道通畅,减轻患者疾病痛苦。
病例1:结核所致右主支气管瘢痕性狭窄



病例2 恶性肿瘤所致气管狭窄

理结果:鳞癌.

07
矽肺门诊
矽肺是最早描述的尘肺,是由于生产过程中长期吸入大量含游离二氧化硅的粉尘所引起的以肺纤维化改变为主的肺部疾病。西安交通大学附属胸科医院(西安市胸科医院)呼吸与危重症医学科开展高频振荡大容量肺部灌洗,减轻患者呼吸困难。

科室骨干医生介绍
CHARACTER INTRODUCTION

主任医师
毕业于第四军医大学,硕士研究生,硕士生导师, PCCM专科培训指导教师,全国呼吸内镜培训教师,曾于2002年7 月–2020年6月空军军医大学(原第四军医大学)唐都医院呼吸与危重症医学科工作,新冠疫情期间负责唐都医院呼吸与危重症医学科重症监护室工作, 2020年7月调入西安市胸科医院工作。熟悉胸部疑难疾病的诊治,尤其擅长呼吸内镜下介入治疗良恶性气道狭窄;内科胸腔镜诊治胸腔积液;光动力治疗呼吸道肿瘤;尘肺大容量全肺灌洗术;超声支气管镜检查术(EBUS-GS/EBUS-TBNA)诊断肺外周结节及纵隔淋巴结肿大。主持多项国内药物临床试验研究,在国内外杂志发表论文十余篇。

赵延军
副主任医师
毕业于陕西中医药大学,2013年完成第四军医大学肿瘤研究生学历。中国抗癌协会陕西省肿瘤分会委员、陕西省介入放射学会委员,曾于2006年--2011年在第四军医大学西京医院消化介入科工作,2011年任第四军医大学唐都医院肿瘤科介入组组长,主要负责肺癌、肝癌、胰腺癌及结直肠癌等肿瘤的治疗,兼负责全科微创介入、体腔热灌注及深部热疗等工作,累计完成各种介入微创手术3000余例,并率先开展了锁骨下静脉港及动脉药盒植入等新技术新业务,完成十余项国际多中心临床III期药物研究,2020年6月调入西安市胸科医院工作。
CHARACTER INTRODUCTION

副主任医师
重症医学二科主任。毕业于郑州大学医学院,任中国医学会陕西重症医学分会委员,曾于2000-2020年就职于空军军医大学(原第四军医大学) 唐都医院心内科和呼吸与危重症医学科,主要从事呼吸危重症救治,擅长急慢性呼吸衰竭、心功能衰竭、大气道狭窄、脑出血/脑梗塞后继发肺部感染、重症肺炎等危重症治疗。在唐都医院担任ECMO治疗组负责人,开展首例ECMO成功救治心脏骤停患者,共开展ECMO 20例。2020年7月就职于西安市胸科医院。

张红军
副主任医师
第四军医大学硕士研究生,副主任医师,曾于2013年-2020年就职于空军军医大学唐都医院呼吸与危重症医学科。任陕西省保健协会早癌筛查专业委员会委员、陕西省保健协会呼吸专业委员会委员、中国病理生理学学会缺氧和呼吸专业委员会委员、中国微生物学会委员及陕西省中西医结合学会呼吸病专委会委员,从事临床诊疗工作20余年,曾任内科副主任2年,主要从事肺部疾病的诊治,尤其擅长肺癌的早期筛查、肺部结节及胸腔积液的诊治,支气管哮喘、慢性阻塞性肺疾病、慢性肺间质纤维化,以及支气管镜检查及镜下治疗,肺癌的化疗、靶向治疗和免疫治疗,尤其对肺癌肿瘤标志物有较深的研究。发表国内外医学论文共20余篇。2020年1月24日至2020年4月16日在武汉火神山医院支援参加抗击新冠肺炎疫情任务。
CHARACTER INTRODUCTION

主治医师
空军军医大学(原第四军医大学)硕士研究生,主治医师,中国抗癌协会、陕西省抗癌协会、纳米肿瘤学专业委员会会员。在西京医院和唐都医院从事临床肿瘤工作10年余,擅长肺癌、胃肠道肿瘤、妇科肿瘤等诊治及靶向、免疫治疗。尤其擅长肺癌个体化、精准化治疗及癌痛的规范化治疗,精通恶性胸腹水的热灌注治疗。参与多项国际、国内药物临床药物试验研究,发表国内外论文10余篇。

王光辉
主治医师
中共党员,2006年在空军医科大学硕士研究生(原第四军医大学)获呼吸内科学硕士学位,2009年获陆军医科大学(原第三军医大学)博士学位,2016-2019年就职于唐都医院呼吸与危重症医学科,主要从事呼吸危重症救治,能熟练操作支气管镜、危重症患者建立人工气道及人工机械通气等,擅长急慢性呼吸衰竭、呼吸道异物、大气道狭窄、重症肺炎、心功能衰竭、重症肺炎、急性呼吸窘迫综合征等治疗。全军呼吸感染病学组委员。发表SCI论文2篇,中文核心期刊论文5篇。
CHARACTER INTRODUCTION

主治医师
毕业于第四军医大学,2014年获空军军医大学(原第四军医大学)硕士学位,曾于2014.06-2020.10就职于空军军医大学唐都医院呼吸与危重症医学科,2020年10月调入西安市胸科医院呼吸与危重症医学科。中国肺癌防治联盟青年委员会委员。目前主要从事肺部疾病的诊治,尤其擅长肺癌的早期筛查、肺部结节及胸腔积液的诊治,以及支气管镜术、胸腔镜检查及治疗、肺癌相关治疗。主持国家基金多项,主持院级新技术新业务1项,发表国内外论文10余篇,参编专著3部。

陈向军
主治医师
中共党员,空军军医大学(原第四军医大学)硕士研究生,曾于2013年6月至2020年8月就职于空军军医大学唐都医院呼吸与危重症医学科。擅长呼吸内科常见病、多发病的诊治,多年从事肺癌、肺部疾病的诊治,对于呼吸内科操作具有丰富的经验。中国呼吸结核分会委员。从事临床药物试验研究多年,发表国内外论文近10篇。
CHARACTER INTRODUCTION

主治医师
中共党员,中国医科大学硕士研究生,主治医师,曾在空军军医大学(原第四军医大学)唐都医院从事呼吸与危重症工作10年余,2020年11月调入西安市胸科医院呼吸与危重症医学科,擅长肺癌的早期筛查、肺部结节及胸腔积液的诊治,以及支气管镜检查及镜下治疗、肺癌的化疗、靶向治疗和免疫治疗,尤其是呼吸道疾病危重患者的救治及管理。任陕西省医师协会重症医学医师分会委员、陕西省医师协会睡眠专业委员会会员、中国人民解放军第十届呼吸内科学专业委员会肺血管病学组成员、中国病理生理学缺氧和呼吸专业委员会委员。

王瑞璇
主治医师
空军军医大学(原第四军医大学)硕士研究生,2016.07—2020.07于唐都医院呼吸与危重症医学科工作。现就职于西安市胸科医院呼吸与危重症医学科。长期从事肺部疾病的诊治。擅长肺部感染性疾病的诊治及肺癌的化疗、靶向治疗等。对呼吸系统疑难、危重症病人的诊治有良好的经验。发表SCI论文7篇,中文核心期刊论文2篇。
CHARACTER INTRODUCTION

主治医师
毕业于空军军医大学(原第四军医大学),2015年获内科学硕士研究生,2015.08—2020.08于陕西省人民医院呼吸与危重症医学科工作。2020年9月就职于西安市胸科医院呼吸与危重症医学科。长期从事肺部疾病的诊治,擅长肺部感染性疾病、肺部结节的诊治及肺癌的化疗、靶向治疗等。对呼吸系统疑难、危重症病人的诊治有良好的经验。发表SCI论文2篇,中文核心期刊论文2篇。

贾丽娟
主治医师
中共党员,毕业于江苏大学临床医学系,2014年获内科学(呼吸内科方向)硕士学位,任陕西省医师协会委员,长期从事呼吸内科常见疾病的诊治,擅长慢性支气管炎、慢阻肺、哮喘、胸腔积液等肺部疾病的诊断、鉴别诊断及治疗。熟练操作纤支镜检查及各种穿刺技术,在国内期刊发表医学论文数篇。
CHARACTER INTRODUCTION

主治医师
毕业于新疆医科大学,2013.07-2019.02就职于新疆生产建设兵团总医院呼吸与危重症医学科,2016.02-2016.09于空军军医大学西京医院呼吸与危重症医学科进修。2019.03调入西安市胸科医院呼吸与危重症医学科。为国家药物临床试验质量管理青年委员。目前主要从事呼吸系统常见多发病、呼吸系统慢性疾病的诊治,尤其是呼吸危重症患者建立人工气道及人工机械通气等方面的治疗,擅长急慢性呼吸衰竭、心功能衰竭、脑出血/脑梗塞后继发肺部感染、重症肺炎、急性呼吸窘迫综合征等相关治疗。

周倩倩
主治医师
毕业于中南大学湘雅医学院,2011年毕业后任职于西安市胸科医院,长期从事呼吸系统常见疾病治疗,擅长慢性支气管炎、哮喘、慢阻肺等慢性肺部疾病的诊治。熟练掌握呼吸科各项诊疗操作技术及内镜下各种诊疗技术,对呼吸急危重症患者的救治有一定的临床经验。
CHARACTER INTRODUCTION

住院医师
毕业于第四空军军医大学(原第四军医大学)临床医学系,2017年获呼吸内科学硕士学位,毕业后就职于西安市胸科医院呼吸与危重症医学科。长期从事肺部疾病的诊治,擅长呼吸内科常见病、多发病的诊治。对呼吸系统疑难、危重症病人的诊治有良好的经验。发表中文核心期刊论文2篇。

杨易帆
住院医师
陕西中医药大学硕士研究生,2015.08硕士毕业后先后就职于武警陕西省总队医院呼吸血液科与陕西省第二人民医院呼吸消化科,现就职于西安市胸科医院呼吸与危重症医学科。长期从事呼吸系统常见疾病治疗,擅长慢性支气管炎、哮喘、慢阻肺等慢性肺部疾病的诊治。对呼吸系统疑难、危重症病人的诊治有良好的经验。
CHARACTER INTRODUCTION

住院医师
毕业于首都医科大学。自毕业参加工作以来,曾在宝鸡高新人民医院、永济市哮喘病医院、五二一医院多个医院工作,在各医院均为科室一线骨干,上班期间得到领导认可及患者好评。曾在空军军医大学唐都医院呼吸科进修工作5年余,积累了丰富的临床经验。现擅长于肺部感染、肺恶性肿瘤、难治性胸水诊治及危重症患者抢救。
来源:西安市胸科医院
喜欢此内容的人还喜欢
原标题:《呼吸与危重症医学科2.0版上线!医疗服务全面升级!》